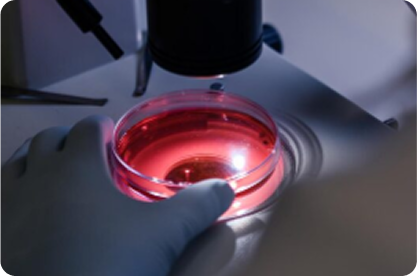

Ophthalmology
Advanced eye care — from vision correction and cataract surgery to retina and glaucoma management for all ages.
Overview
The Ophthalmology Department at Quality Health Care Hospital, Kupwara provides comprehensive eye care using modern diagnostics and evidence-based treatments. Our ophthalmologists, vitreoretinal and glaucoma specialists, optometrists and trained nursing staff deliver personalised care — from routine vision checks and medically managed eye conditions to complex surgical procedures — so patients can see clearly and live confidently. We combine patient-centred counselling with NABH-standard surgical facilities, digital imaging and coordinated multispecialty support to ensure safe outcomes and fast recovery. Many diagnostic and surgical ophthalmic services are available under PMJAY / SEHAT and ECHS for eligible patients.
Sub Specialities

Cataract & Refractive Surgery
Phacoemulsification and intraocular lens implantation to restore vision, plus refractive procedures and vision-correction counselling.

Retina & Vitreoretinal Services
Diagnosis and management of diabetic retinopathy, retinal detachment, macular degeneration and other retinal disorders with laser and surgical options.

Glaucoma Care
Early detection, medical control and surgical procedures to preserve vision in patients with raised intraocular pressure and optic nerve disease.
Treatments & Ailments Options
"Advanced treatments and alignment options for better mobility and recovery."


Select an item to view its description.
Latest Technology
Our eye care services use precise diagnostics and modern surgical tools to ensure safe, effective treatment:

Digital Slit Lamp

Optical Coherence

High-Precision IOLs

Vitrectomy Surgical

Laser Platforms

Visual Field

Vision Screening Tools

Digital Slit Lamp

Optical Coherence
High-Precision IOLs
Meet Our Doctors
Meet our dedicated team of doctors, including specialists in gastroenterology, pediatrics, ophthalmology, advanced laparoscopic surgery, cardiology, and more. With ACLS & ATLS-certified experts, we ensure the highest level of safety and advanced life support.

Dr. Wani Abdul Majid
Consultant Gastroenterologist
MBBS, MD (Medicine), MRCP (UK), Certified in ACLS & ATLS.
Dr. Mubeena Majid
Gynaecologist
MBBS, Certified in BCLS & ACLS.

Dr. Shahnawaz Rasool
Urologist
MBBS (2010), MS (General Surgery) SKIMS Srinagar (2014), DNB (Urology) (2018).

Dr. Malik Manzoor
ENT (Ear‑Nose‑Throat, Head & Neck Surgeon)
MBBS, MS (ENT) – Specialised in Otolaryngology and Head & Neck Surgery.
Dr. Faisal Qayoom Shah
Ophthalmologist Consultant
MBBS (Sher-i-Kashmir Institute of Medical Sciences, 2012).

Dr. Omar Masood
Consultant & Head of Pediatric Surgery
MBBS, MS (General & Minimal Access Surgery) SKIMS; DrNB (Paediatric Surgery) Delhi.

Dr. Ghulam Mustafa Dar
Advanced Laparoscopic Surgeon
MBBS, MS (General Surgery).

Dr. Saleem Ahmad Shah
General Physician
MBBS (General Medicine & Emergency Care).

Dr. Abdullah Bin Tariq
General Physician
MBBS, MD (Medicine).

Dr Berkheez Shabir
Consultant – Obstetrics & Genecology
MBBS, MS (Obstetrics & Gynaecology).

Dr. Zahoor Hussain Daraz
Consultant Pediatrics
MBBS (GMC Barisal), MD (Pediatrics) – BSM Medical University.

Dr. Imran Sofi
Nephrologist
MBBS, MD (Medicine), DM (Nephrology) – SKIMS, Srinagar.

Dr. Shafeeq Zargar
Consultant Cardiologist
MBBS, MD (Medicine), Fellowship in Electrophysiology (FEHI, New Delhi).

Dr. Zubair Ahmed Geelani
Orthopaedic Surgeon
MBBS, MS (Orthopaedics) – Kashmir University / GMC Srinagar (2023).

Dr. Mushtaq Zargar
Gynecology & Obstetrics
MBBS, MS (Obstetrics & Gynaecology).

Dr Kaiser Habib
Gynaecology & Obstetrics
MBBS, MS (Obstetrics & Gynaecology).

Dr. Sameer Ahmad Lone
Gynaecologist
MBBS, MD (Obstetrics & Gynaecology).

Dr. Sheikh Mohammad Maqbool
General Surgeon
MBBS, MS (General Surgery).
Our Patients, Their Stories




